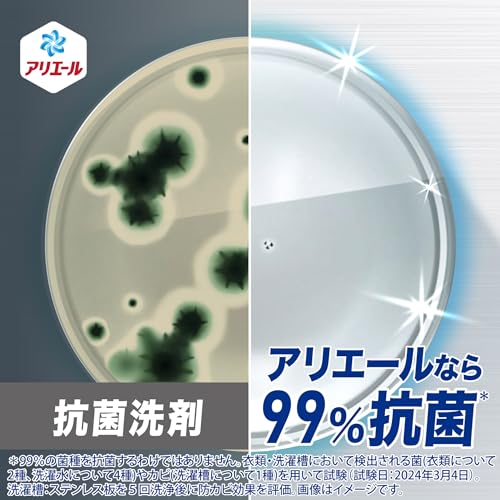

アリエール 洗濯洗剤 液体 超抗菌プレミアム 部屋干し超消臭 天日干し級にさわやかな香り 詰め替え 625g
¥450税込
まるごと抗菌 衣類・洗濯水・洗濯槽 *全ての菌の増殖を抑えるわけではありません。
干した衣類も、部屋までまるごと消臭*P&G調べ。ニオイの度合いにより、落ち方の程度は異なります。
最高レベルの抗菌成分 *アリエール超抗菌プレミアムシリーズ比。
10%濃縮同じ洗濯洗剤量で今までより+5枚洗える*2023年アリエール超抗菌プレミアムシリーズ比。同じ洗濯水量設定の場合。
すすぎ1回OKタテ・ドラム式対応。自動投入洗濯機にも。
-----------
-配送について (1営業日~4営業日内に発送予定*一部の商品は除く)
商品によって配送業者や配送手段がことなります。(*ヤマト・アマソ"ン・郵便局・佐川・赤帽:ヨドバシなど)
一部の商品では荷物番号が無い配送手段での出荷にて対応することがございます。お客様側で荷物状況の確認が出来ない事もありますので、その際は店舗まで状況確認でのご一報いただきますよう何卒宜しくお願い致します。配送スタッフの負担を少しでも業界全体で減らす活動に参加しておりますので、不在時の置き配達での対応がある場合、その点はご了承くださいませ。